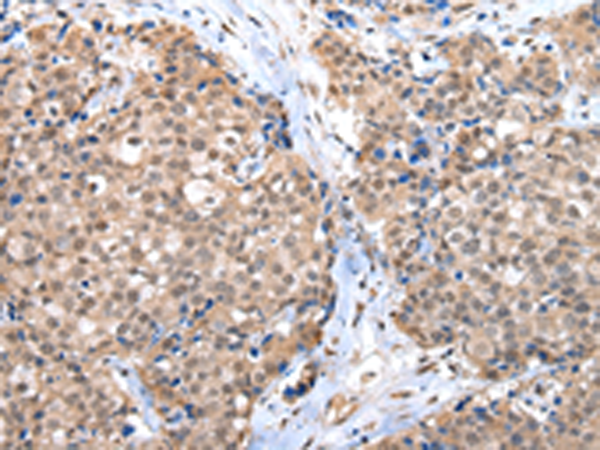
一抗

中文名稱: 兔抗CTBP1多克隆抗體
|
Background: |
This gene encodes a protein that binds to the C-terminus of adenovirus E1A proteins. This phosphoprotein is a transcriptional repressor and may play a role during cellular proliferation. This protein and the product of a second closely related gene, CTBP2, can dimerize. Both proteins can also interact with a polycomb group protein complex which participates in regulation of gene expression during development. |
|
Applications: |
ELISA, WB, IHC |
|
Name of antibody: |
CTBP1 |
|
Immunogen: |
Synthetic peptide of human CTBP1 |
|
Full name: |
C-terminal binding protein 1 |
|
Synonyms: |
BARS |
|
SwissProt: |
Q13363 |
|
ELISA Recommended dilution: |
2000-5000 |
|
IHC positive control: |
Human breast cancer |
|
IHC Recommend dilution: |
50-250 |
|
WB Predicted band size: |
48 kDa |
|
WB Positive control: |
293T and NIH/3T3 cell |
|
WB Recommended dilution: |
500-2000 |


 購物車
購物車 幫助
幫助
 021-54845833/15800441009
021-54845833/15800441009